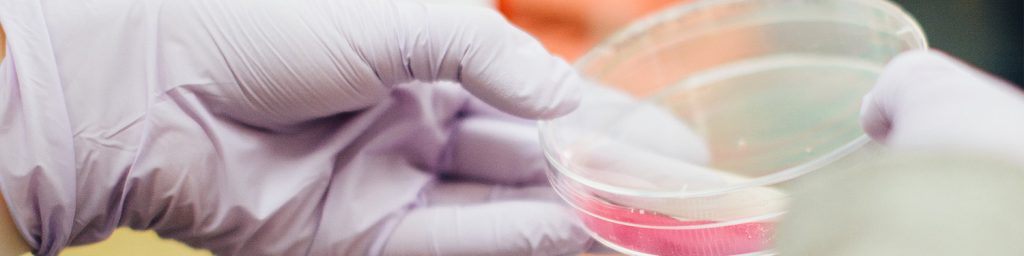
Sleep debt increasing the risk for dementia blood test

DISAJP NEWS Vol.28 July 4th, 2020
Dementia Improved Support Association of Japan
This email is sent to those who subscribe to DISA NEWS, the newsletter from the Dementia Improved Support Association of Japan.
We distribute the newsletter on the 4th of each month to all the subscribers for delivering valuable information, aiming to achieve the dementia-free world.
We offer sincere prayer for the repose of the souls of those who lost their lives with COVID-19 spreading across the world, and our deepest sympathy to those infected. We wish them quick recovery, as well as hoping that everyone in difficulties get life back to normal soon.
We stay active on our mission hoping to contribute to avoiding the elderly’s risk for death from the virus by supporting cognitive functions’ recovery to help them get peaceful days back.
Contents
〇 Sleep debt increasing the risk for dementia
〇 Research started on blood test enabling early detection of dementia (Japan’s National Center for Geriatrics and Gerontology)
〇 Get through the present with Kouka, and start new lifestyle
〇 Clinical trial of Kouka (recruitment of participants will be restarted after resume of international shipping)
〇 Sleep debt increasing the risk for dementia
Have you ever heard the word “sleep debt”? It is a term proposed by William C. Dement, a professor at the Stanford University. Sleep debt means accumulation of insufficient sleep like debt, potentially causing negative effects physically or mentally.
A slight shortage can pile up to make “excessive debt”, which deteriorates the quality of life or work, or worse, leads to illness such as depression, cancer or dementia. Actually, short sleepers are reported to have higher risk for dementia.
Alzheimer’s disease is caused by abnormal accumulation of protein waste called beta amyloid in the brain, which destroys brain neurons and disrupts memory or thought.
Waste materials generated in human body are known to be transported to liver or kidney trough the blood and lymph systems, and then decomposed or excreted.
Unlike this process, excreting mechanism in the brain had been unclear, but recent research revealed there is a similar system to convey the wastes out of brain.
The brain and spinal cord have a liquid called cerebral spinal fluid, which flows into the brain through the perivascular space around cerebral arteries.
The fluid then flow out of the brain through the perivascular space around cerebral veins. This cycle of the fluid, flowing along arteries and then veins, washes away the waste from the brain.
Recently, this flushing system was found to be working during sleep better than wakefulness. Continual poor quality sleep should be responsible for insufficient excretion and more wastes accumulated.
(Reference: Science Magazine Newton)

While being forced to stay home by COVID-19, people with dementia tend to decline in memory, mobility or other functions.
Their families are bearing more burden during day care facilities are unavailable, so both are suffering more stress.
We recommend a supplement Antistress, containing natural crude drug increasing serotonin known as a happy hormone.
Feel free to contact us via email if you are interested.
〇 Research started on blood test enabling early detection of dementia (Japan’s National Center for Geriatrics and Gerontology)
On June 22, the National Center for Geriatrics and Gerontology in Aichi announced to start R&D on a method to examine dementia related materials contained in a small blood sample, enabling early diagnosis or presymptomatic risk prediction.
They have launched a cooperative project named BATON along with domestic research institutions and private companies.
BATON stands for Blood-based Amyloid, Tau and Other Neuropathological Biomarkers Project.
This project is not designed to “directly score a goal” like therapeutic drug development, but is crucial for boosting development of effective treatment or prevention, as it will help diagnosis or risk estimation of dementia in a safe, easy and inexpensive manner.
Baton’s logo represents a hope for the project to be baton pass from dementia researchers to pharmaceutical companies, clinicians and aged individuals.
Baton is expected to contribute to human healthcare by showing its presence to the world,
as relay racing powered by Japan’s unique technique and teamwork.
The ultimate target is to create a comprehensive blood testing method from combined outcomes
from multiple research conducted in parallel, intended to achieve the practical use in five years.
Testing with a small blood sample will enable lower cost for patients with higher accuracy and speed of diagnosis,
as well as contributing to development of treatment or prevention.
https://www.ncgg.go.jp/camd/news/20200623.html
〇 Get through the present with Kouka, and start new lifestyle
Kouka contains reishi extract as the main ingredient, which improves microcirculation and strengthen vessels.
We have many feedbacks from those whose blood sugar or pressure was regulated back to almost normal, besides improvement of cognitive functions.
The connection between COVID-19 and thrombosis is now attracting attention.
BBC news reported that about 30% of severe patients of the virus had thrombosis.
It suggests respiratory symptoms are not necessarily caused by the virus itself, but likely to be connected to thrombosis.
A blocked vessel in the heart or lung increase the fatality in cardiac or lung infarct, which is further elevated by pneumonia.
Doctors were not sure why so many young people died from the viral pneumonia in the United States, Italy and other countries,
but it makes sense if it is complicated with cardiac or lung infarct.
The breathing difficulty in a COVID-19 patient is caused by a blood clot in lung. Similarly,
taste or smell disorders are caused by a clot in a neurovascular connected to these senses.
Here are characteristics of severe COVID-19 patients:
– Male
– Smoker
– Having lifestyle disease such as hypertension, diabetes, hyperlipidemia etc.
– Overweight
– Having malignancy
Smoking, overweight or a lifestyle disease weakens vessel functions. Generally, male is considered to have higher risk for damaged vessels than female.
Thus, those with higher risk for vessels are likely to become severe patients.
A viral attack to a vessel causes an inflammation, which triggers another, potentially leading to a great deal of clots that makes the case severer.
This might be the reason why the patients are polarized to very mild and severe ones.
You could say keeping vessels young and healthy works as an important prevention.
Proper amount of Kouka will contribute to preventing a severe case by keeping your vessels strong,
as well as improving cognitive functions.
It will support your new lifestyle for better new normal.
〇 Clinical trial of Kouka (recruitment of participants will be restarted after resume of international shipping)
Kouka is a processed food product of Ganoderma Lucidum (reishi), patented in Japan as a composition of matter to ameliorate cognitive dysfunctions.
Almost 100% of Kouka users who took it for 3 months experienced alleviation of cognitive dysfunctions and life style diseases.
Currently, our 3 months trial program is in the face of difficulty due to the import limit for infection control in many countries, causing return of the packages.
We decided to suspend the program for overseas applicants for some time.
The program will be restarted after international shipping issues are cleared.
Recruitment will be also resumed and conducted until reaching the capacity,
after confirming all the applications already submitted.
Thank you very much for your understanding and support to our activities.
The world is fighting against the COVID-19.
We greatly appreciate medical professionals for their dedicated work in such a tough situation.
We continue our mission aiming to see more dementia free communities in the world.
We believe taking proper amount of reishi, a gift of nature, is essential for normalization of microcirculation,
which helps cognitive functions’ recovery.
Our association has conducted physiological researches to prove cognitive functions can recover,
as well as offering a wide range of awareness campaigns.
We strongly hope our valuable information reaches as many people as possible.
Smiles in families are our joy and drive.
We deliver further information at the official website, so please check it out.
https://disajp.org/
We distribute valuable information on the 4th of each month to the world for reducing suffer of dementia. We welcome your feedback.
You can purchase the high quality reishi supplement Kouka effective for improving cognitive functions at DIS SHOP.
https://dis-shop.info/